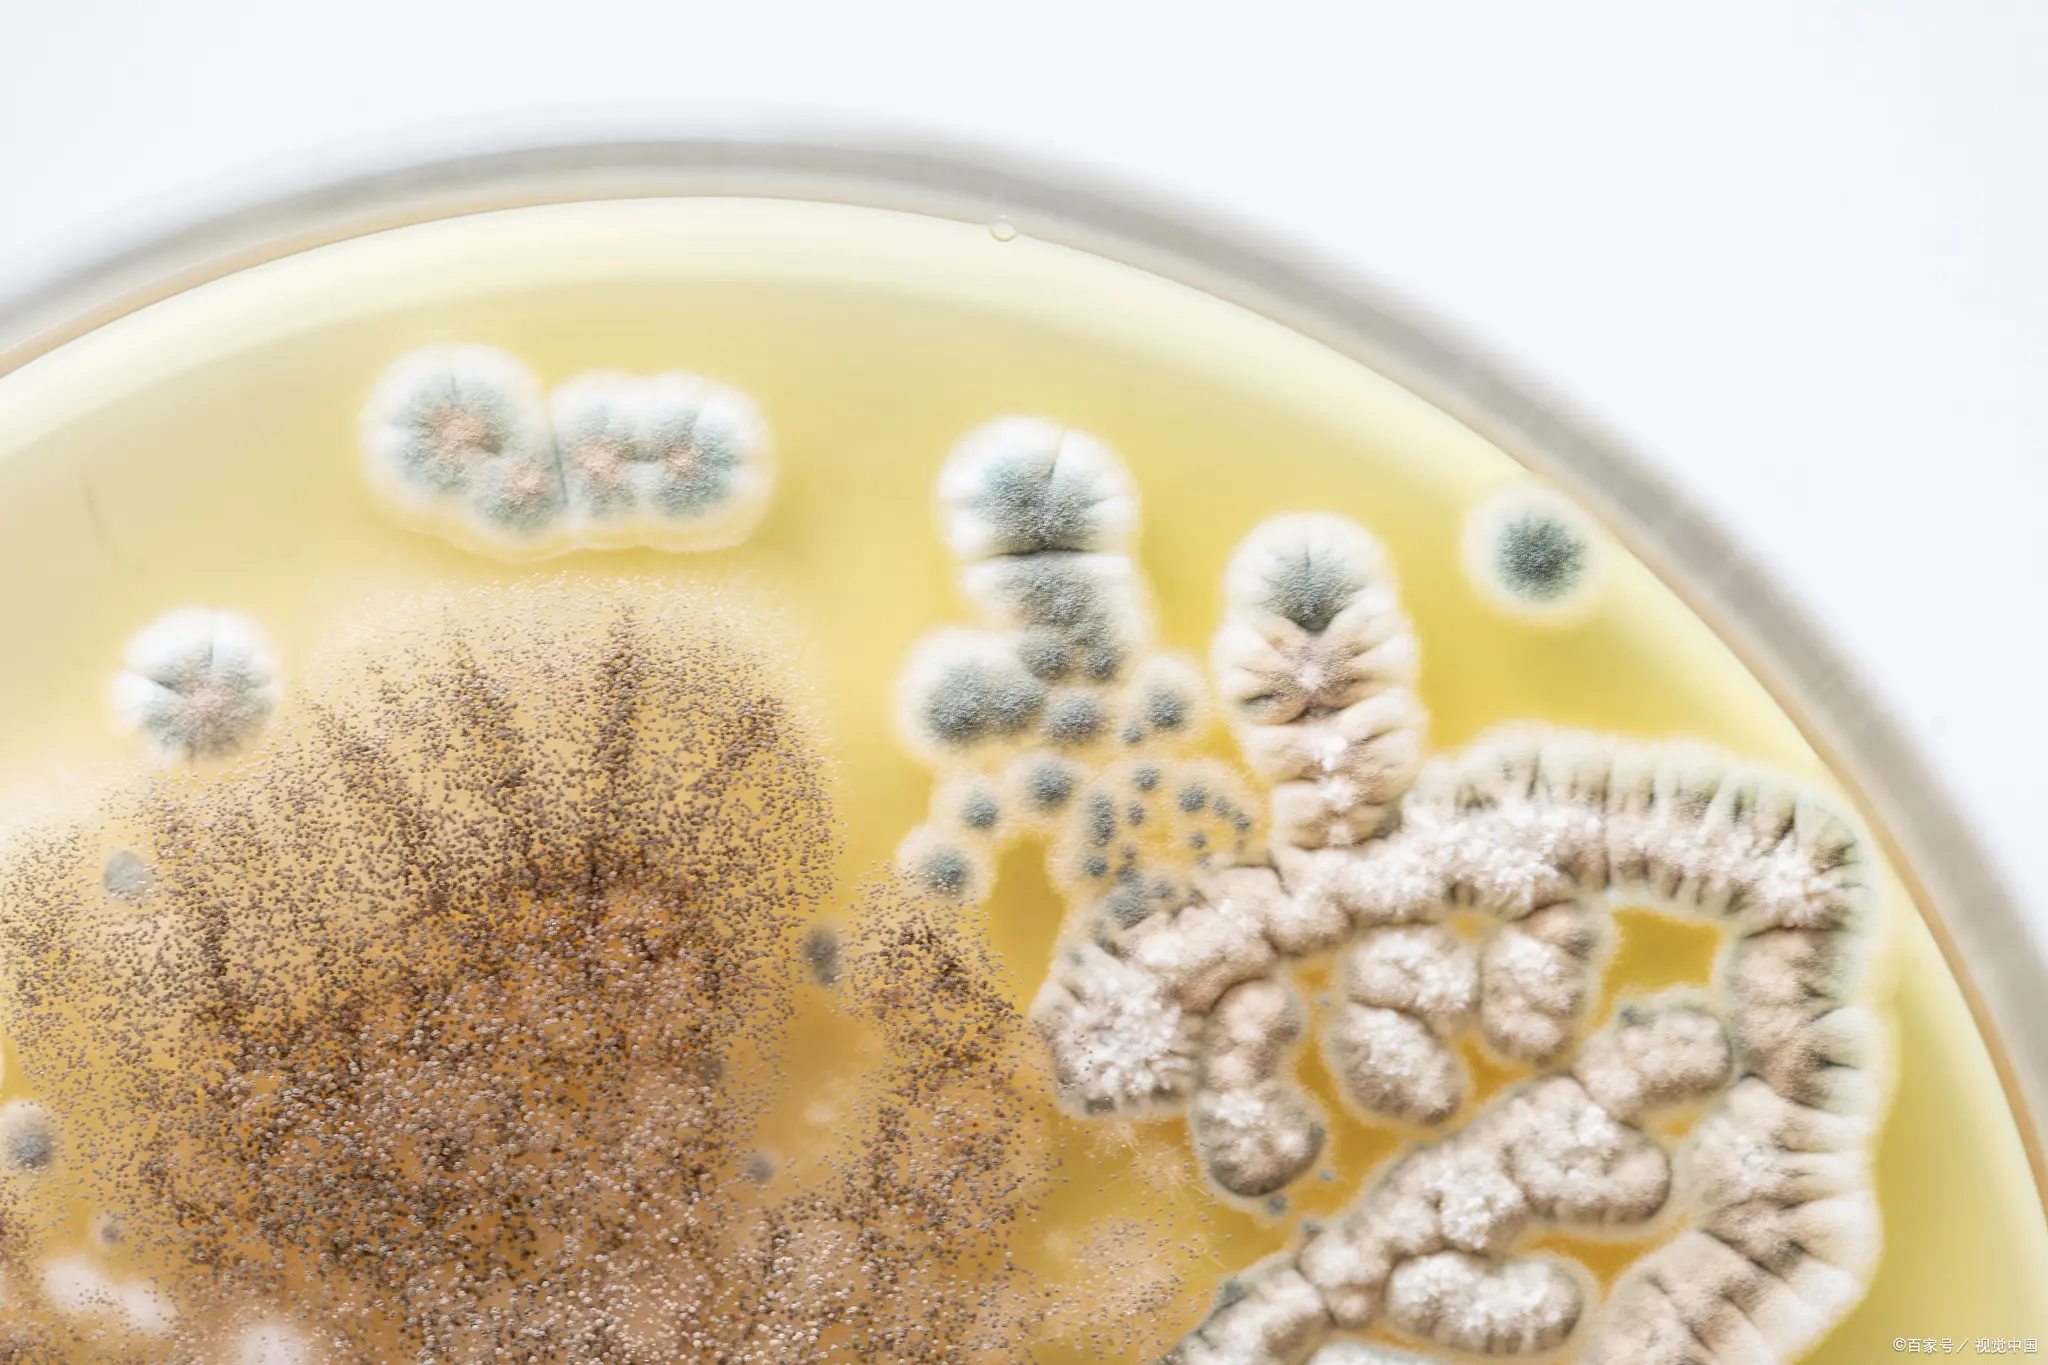
霉菌酵母菌检验常见问题 霉菌酵母菌检验常见问题

《十万个为什么》霉菌酵母菌检测常见问答精选
发布时间:2022-07-15 浏览次数:3166
汇聚行业网友见解,传递微生物检测知识,本次列出的问题均是霉菌酵母菌检验过程中提问频次较高的问题,食品微生物检测小编咨询专家老师后汇编,希望可以帮助朋友们对检验过程中遇到的问题有新的理解。大家感兴趣的、比较关注的问题,也可以后台留言,我们一起交流探讨!
问1、霉菌正置培养如何避免菌落蔓延呢?因为很多时候培养一天就开始有长菌,而且一蔓延整个培养箱就交叉污染了。
答:不要经常去动平板,如果整筐放的话,就不要动,打开培养箱门,隔着平皿盖直接观察。如果有蔓延的先挑出来。只要你动了培养皿,无论正置或倒置,都会增加霉菌孢子的扩散和蔓延。
问2、霉菌的培养湿度有要求吗?有没有标准,我在有的地方见过是65-85%之间。
答:霉菌的培养湿度没有标准,因为不同的实验室,比如南方的、北方的实验室空气湿度要求是不一样的。霉菌的培养还是应该控制其湿度的,湿度太高霉菌会蔓延,湿度太低培养皿就干燥了,霉菌生长受影响,所以实验室应该自行规定。
问3、霉菌培养箱的霉菌怎么处理?
答:平时最简单的就是先喷一些酒精,喷酒精杀菌,然后挥发干了以后你测一下,如果还是不行的话,我们的培养箱如果里面有电源插座的话也可以加一盏紫外灯。插在里面,它会产生一些臭氧,也会杀死一些表面的菌,如果最麻烦严重污染的我们建议用甲醛熏蒸,甲醛对培养箱没有任何的腐蚀作用,反正闷在里面。
问4、食品企业发生天花板长霉情况,请问有什么办法处理?
答:天花板长霉,原因是有冷凝水、温度又合适。如果加工环境不可更改的情况下,可以使用一些防霉的材料。对于已经有霉菌的情况下,使用清洗剂和消毒剂对天花板表面进行清洁、消毒。但一定要做好高空作业人员的安全。
问5、食品霉菌检测要正置培养,每次培养都和倒置培养区别很大,倒置几乎没霉菌生长,但正置就很容易染菌,是什么原因呢?
答:霉菌的特性是由蔓延性,且由于培养箱加热,培养箱内部还有风机使内部气流在旋转,如果有一个样品有霉菌,那么菌丝就会通过缝隙往上爬,且随着孢子会脱落而且非常轻,培养箱风机吹出的风把孢子吹散,停到盖子上设置通过盖子之间的缝隙污染了其他样品,但同一叠随着菌丝蔓延,那个过培养皿直接蔓延到另外一个培养基上,一个蔓延一个,那么一叠被污染的情况会更严重。减少堆叠平板数。
问6、对于食品工厂来说对于酵母和霉菌是必检项吗?还是根据企业的自身情况?
答:对于终产品是否要检测霉菌和酵母,依赖的是产品标准。对于环境是否要检测霉菌和酵母,一方面看你的产品是否是霉菌和酵母易感产品类型,如果是,则环境中霉菌和酵母是需要检测的。
问7、面包产品切片存放后发现有黑色的霉菌 一般是什么原因呢?
答:如果存放时,是密封包装则是切片或生产后带入。如果非密封包装,则存放的地方也会对其污染。其次是环境,如果存放的环境是冷藏环境,对环境欢度进行监测,是否达到所需的温度。
问8、培养箱受到霉菌污染如何清洗,培养箱不可拆除?
答:75%酒精和新洁尔灭两种消毒剂对培养箱进行全面的消毒,且培养箱最好带有紫外消毒、臭氧消毒,且消毒后不要马上用,消毒完后放置几天后再使用。
问9、酒精对霉菌孢子的杀灭作用如何?另外,臭氧对环境霉菌的杀灭作用如何?
答:臭氧有作用,但需要注意浓度和时间。但要注意残留,臭氧工业卫生标准:国际臭氧协会:0.1 ppm,接触10小时。美国:0.1 ppm,接触8小时。浓度在0.1 ppm左右已经能够有效地抑制霉菌。
问10、车间和洁净间空气中酵母菌霉菌检测,有没有标准可依据?
答:GB 14881的附录推荐了需要进行空气中的霉菌酵母监测。另外和空气沉降相关的法规标准:GB 15979-2002 一次使用卫生用品卫生标准;GB 15982-2012 医院消毒卫生标准;GB/T 18204.3-2013 公共场所卫生检验方法 第3部分 空气微生物;GB/T 16294 医药工业洁净室(区)沉降菌的测试方法;GB 50687-2011 食品工业洁净用房建筑技术规范;其中,只有GB 50687-2011 食品工业洁净用房建筑技术规范 中提到了沉降真菌限值。
问11、空气环境的霉菌限制标准是多少?
答:GB 14881中规定:结合生产实际情况确定监控指标限值。因为每个工厂的设施情况、生产产品类型都不一样。
问12、霉菌培养箱经常会使接种平板受到污染,怎么解决?
答:
- 做好培养箱的日常维护 。发现有样品检出大量霉菌时。增加箱体的消毒颇率.到少培养个周期需要清洁 (75%乙酶)与消毒(含氨消剂)
- 隔离长霉菌的平板 (如用塑料盒单独感放)
- 增加空白平皿的对照数量 ,在箱体靠近风口的地方放置,以检查污染的位置
- 尽量用质量好的平皿 ,避免平血底与盖编障过大.有些玻璃平血口边缘不平整需要剔除
- 放置平皿时注意不要靠近风口,培养至第3天如果发现长霉菌用封口膜独绕一圈以避免孢子飘出。











